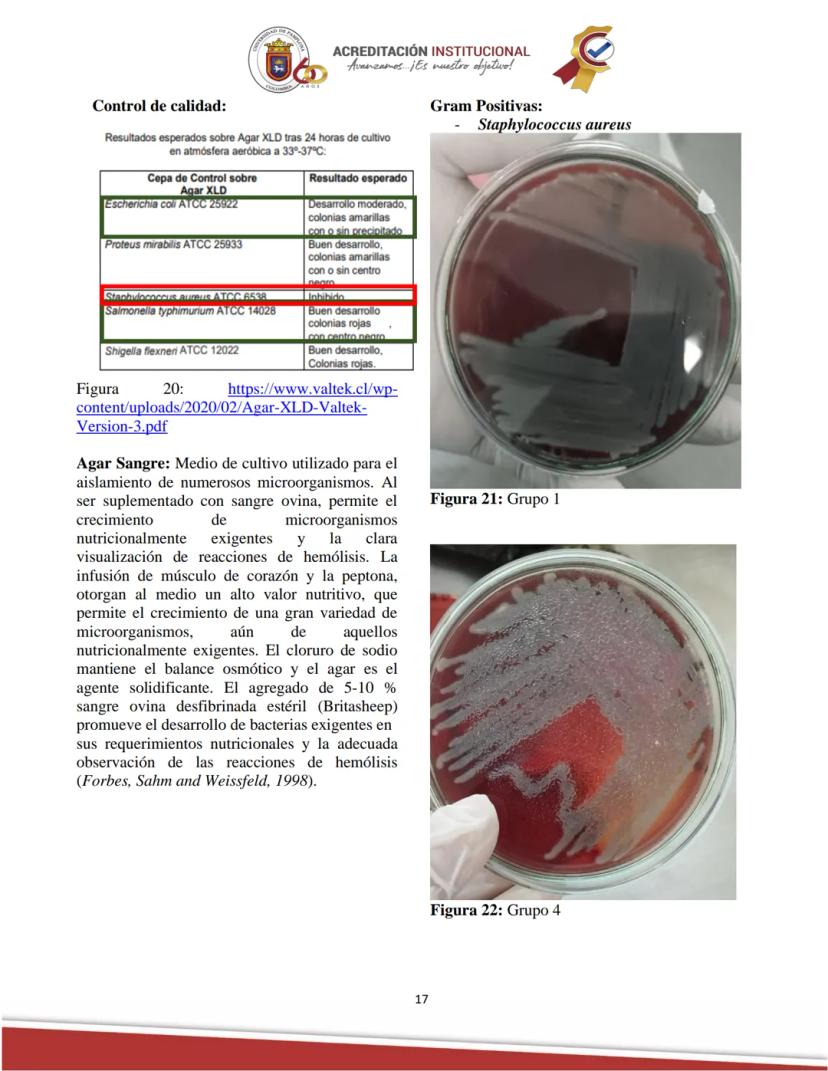
Page 17
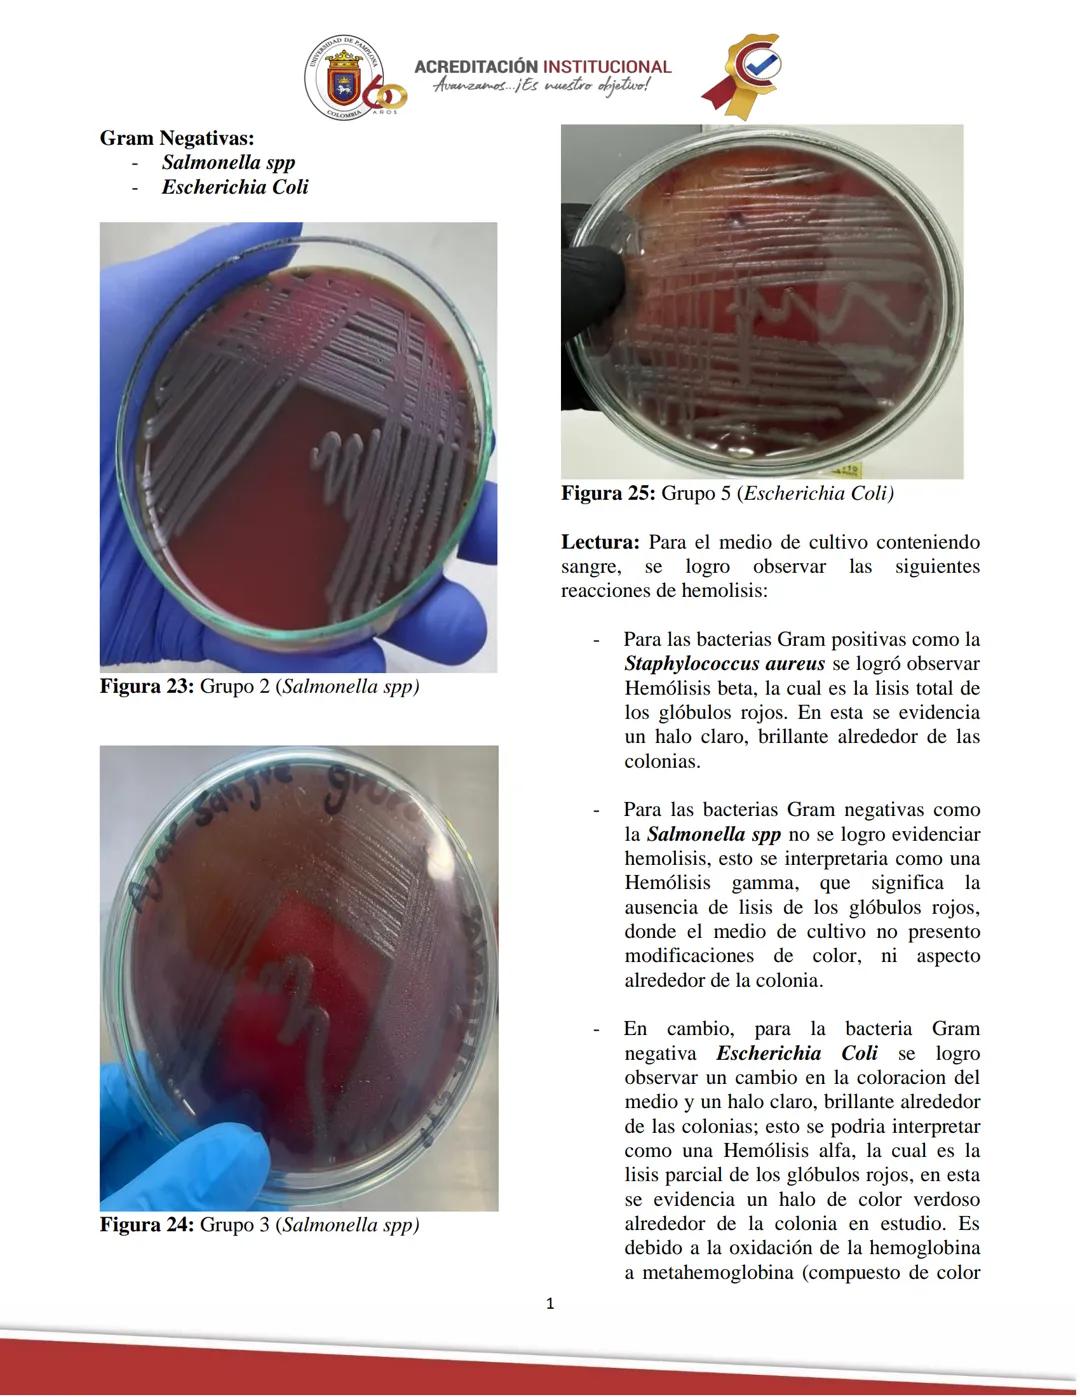
ACREDITACIÓN INSTITUCIONAL
Avanzamos... ¡Es nuestro objetivo!
Universidad De Pamplona
Facultad de Ciencias Agrarias
Departamento de Medicin
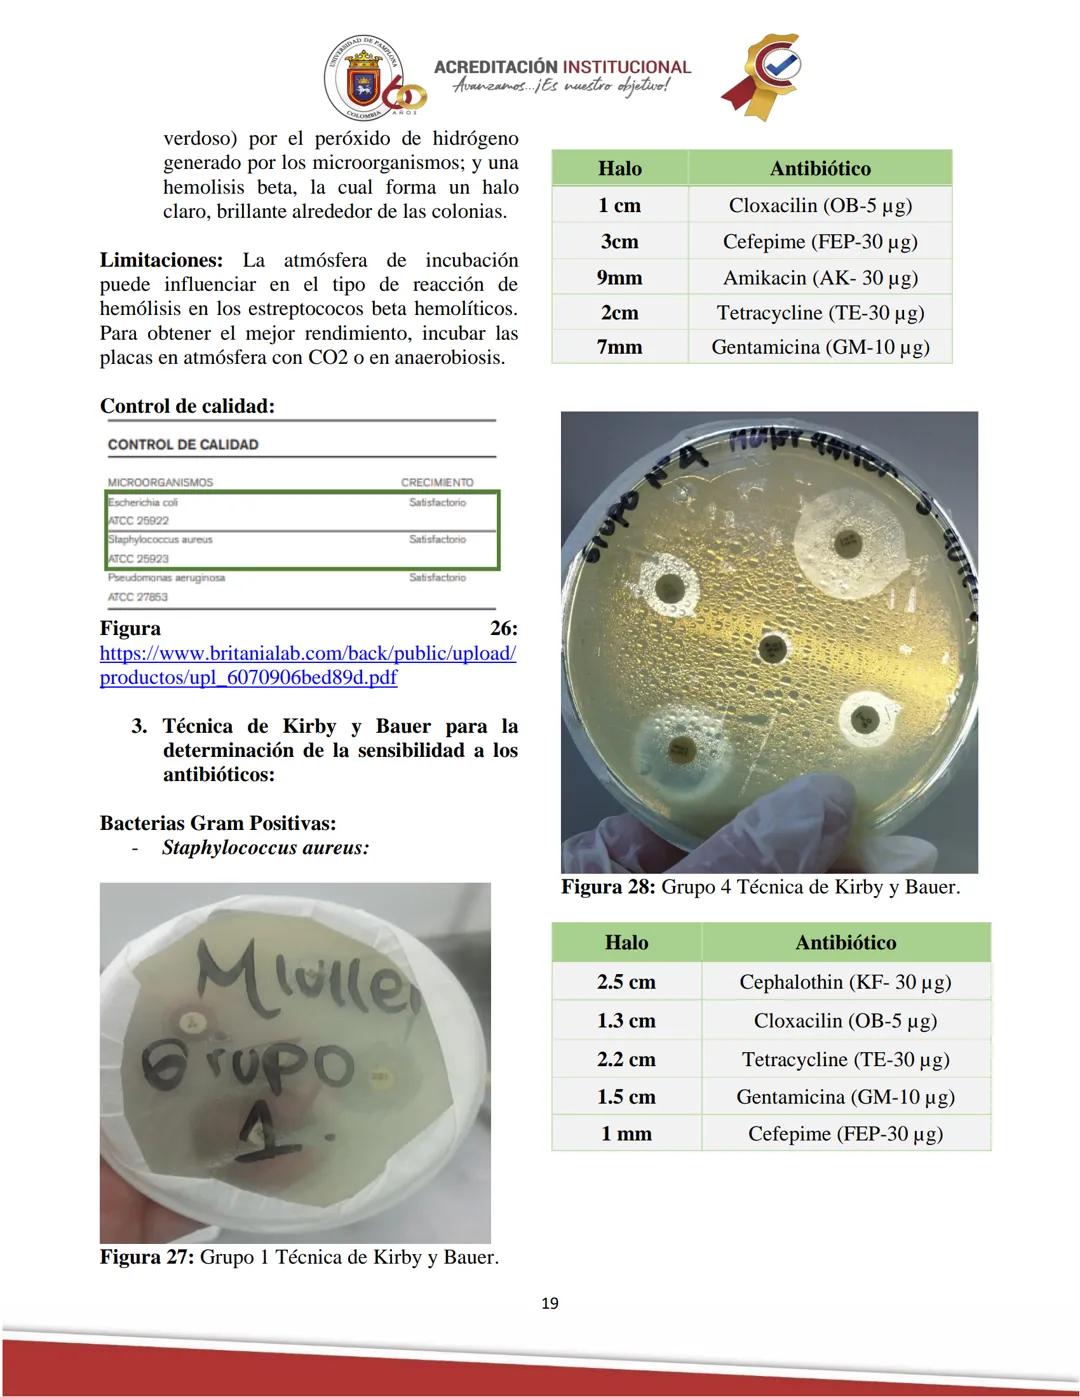
ACREDITACIÓN INSTITUCIONAL
Avanzamos... ¡Es nuestro objetivo!
Universidad De Pamplona
Facultad de Ciencias Agrarias
Departamento de Medicin

Las infecciones bacterianas representan un desafío importante tanto para la... Mostrar más
Análisis de Microbiología Veterinaria: Informe del Laboratorio

Introducción a la Práctica de Diagnóstico Bacteriano
El diagnóstico bacteriano es fundamental para identificar agentes patógenos y establecer tratamientos efectivos en medicina veterinaria. Esta práctica, desarrollada en la Universidad de Pamplona (Facultad de Ciencias Agrarias, Departamento de Medicina Veterinaria), busca explorar las técnicas fundamentales para el aislamiento, identificación y caracterización de bacterias causantes de enfermedades infecciosas.
A través de procedimientos como la siembra en medios de cultivo, tinciones y pruebas de sensibilidad a antibióticos, los estudiantes adquieren habilidades esenciales para el diagnóstico microbiológico. Estas competencias son indispensables para futuros médicos veterinarios, quienes enfrentarán constantemente enfermedades de origen bacteriano en su práctica profesional.
El dominio de estas técnicas no solo permite identificar al patógeno causante de una infección, sino también determinar el tratamiento más adecuado, contribuyendo directamente a la salud animal y la prevención de zoonosis.
💡 Dato clave: Las técnicas de diagnóstico bacteriano constituyen la base para el control y erradicación de enfermedades infecciosas, siendo fundamentales tanto para la salud animal como para la salud pública.

Fundamentos del Diagnóstico Bacteriano
Las infecciones bacterianas pueden originarse de dos maneras principales: endógenas (causadas por la microflora normal del huésped) o exógenas (provenientes del ambiente). En áreas desarrolladas, predominan las infecciones endógenas, mientras que en regiones con mayores índices de pobreza, son más comunes las exógenas.
Las rutas de transmisión bacteriana varían considerablemente e incluyen la vía fecal-oral, aérea, transcutánea, parenteral, sexual y mediante vectores como artrópodos. Conocer estas vías es esencial para establecer medidas efectivas de control y prevención.
La siembra bacteriana es el proceso de colocar bacterias en medios de cultivo para su estudio. Esto puede realizarse a partir de muestras biológicas (como orina o pus), para control de calidad (en alimentos o medicamentos) o mediante subcultivos. La identificación bacteriana requiere conocer tanto su morfología microscópica como macroscópica, observando las características de las colonias en los medios de cultivo.
Las bacterias poseen una notable versatilidad para utilizar diversos compuestos nutritivos, desde moléculas inorgánicas simples hasta compuestos orgánicos complejos. Esta capacidad diferencial de utilización de nutrientes constituye la base para su identificación tradicional en el laboratorio.
🔬 Perspectiva práctica: El diagnóstico bacteriano no solo identifica al patógeno, sino que también proporciona información crucial sobre su resistencia a antibióticos, permitiendo seleccionar el tratamiento más efectivo y evitando la propagación de cepas resistentes.

Tipos de Medios de Cultivo y su Utilidad Diagnóstica
Los medios de cultivo son fundamentales en el diagnóstico bacteriológico y pueden diseñarse para diversos propósitos: aislar tipos bacterianos específicos, diferenciar grupos relacionados, identificar microorganismos en muestras ambientales, evaluar efectos de sustancias antimicrobianas o caracterizar bacterias según sus capacidades metabólicas.
Medios Enriquecidos
Los medios enriquecidos están formulados para fomentar el crecimiento de bacterias exigentes que requieren nutrientes específicos. Contienen componentes adicionales como suero sanguíneo o extractos de tejidos que proporcionan una rica fuente nutritiva.
Ejemplos destacados incluyen el agar sangre, que permite el crecimiento de patógenos exigentes como Streptococcus pneumoniae y facilita la identificación de patrones de hemólisis (α, β o γ). Otro ejemplo importante es el agar chocolate, enriquecido con sangre calentada que libera factores esenciales para bacterias como Haemophilus influenzae.
A diferencia de los medios selectivos, los medios enriquecidos no están diseñados para inhibir microorganismos, sino para proporcionar un ambiente óptimo para el crecimiento de aquellos con requerimientos nutricionales específicos.
Medios Selectivos
Estos medios contienen sustancias que inhiben el crecimiento de ciertos microorganismos mientras permiten el desarrollo de otros. Incluyen sales, colorantes, antibióticos u otros compuestos químicos que actúan como agentes selectivos.
El agar MacConkey es un ejemplo clásico, que selecciona bacterias gramnegativas al contener sales biliares y cristal violeta que inhiben bacterias grampositivas. El agar manitol salado es otro medio selectivo importante, cuya alta concentración de sal permite el crecimiento de estafilococos mientras inhibe otras bacterias.
Estos medios son invaluables en microbiología clínica para aislar patógenos específicos de muestras complejas como sangre o heces, donde pueden existir poblaciones microbianas mixtas.

Medios Diferenciales e Identificación Bacteriana
Medios Diferenciales
Los medios diferenciales permiten distinguir entre especies bacterianas basándose en reacciones bioquímicas visibles. Contienen sustratos o indicadores que producen cambios visuales cuando son metabolizados por ciertos microorganismos, facilitando la identificación de diferentes colonias en muestras mixtas.
El agar MacConkey, además de ser selectivo, es también diferencial: las bacterias fermentadoras de lactosa forman colonias rojizas, mientras que las no fermentadoras aparecen incoloras. Otro ejemplo es el agar eosina-azul de metileno (EMB), que diferencia Escherichia coli (colonias verde metálico) de otras bacterias gramnegativas no fermentadoras.
Estos medios resaltan diferencias metabólicas entre microorganismos y facilitan la identificación rápida en laboratorios clínicos y de diagnóstico.
Identificación de Grupos Bacterianos Específicos
Bacterias Hemolíticas
Se identifican principalmente en agar sangre, observando el tipo de hemólisis:
- β-hemólisis: Halo claro alrededor de las colonias (ej. Streptococcus pyogenes)
- α-hemólisis: Halo verdoso alrededor de las colonias (ej. Streptococcus pneumoniae)
- γ-hemólisis: Ausencia de hemólisis
Enterobacterias
Se utilizan medios como agar MacConkey y EMB para diferenciar fermentadoras de lactosa de no fermentadoras. Las pruebas bioquímicas complementarias incluyen catalasa, oxidasa, ureasa y fermentación de azúcares. Sistemas como API 20E permiten la caracterización de enterobacterias mediante pruebas bioquímicas miniaturizadas.
Anaerobios
Requieren condiciones especiales de cultivo con baja o ausencia de oxígeno. Se utilizan medios específicos como agar Schaedler o tioglicolato, y sistemas de incubación anaeróbica. Las pruebas de identificación incluyen catalasa (generalmente negativa), esporulación y métodos moleculares como PCR.
💡 Recuerda: La correcta selección del medio de cultivo es fundamental para el aislamiento e identificación de bacterias patógenas, ya que cada medio está diseñado para favorecer el crecimiento de ciertos microorganismos mientras inhibe o diferencia otros.

Identificación de Staphylococcus y Clasificación de Antibióticos
Identificación de Staphylococcus
Para identificar bacterias del género Staphylococcus, se emplean pruebas específicas como:
- Cultivo en agar sangre y agar manitol salado: Staphylococcus aureus fermenta manitol, produciendo un cambio de color en el medio.
- Prueba de catalasa: Permite diferenciar estafilococos (catalasa positivos) de estreptococos (catalasa negativos).
- Prueba de coagulasa: S. aureus es coagulasa positivo, diferenciándolo de otras especies como S. epidermidis y S. saprophyticus.
- Técnicas moleculares: PCR para genes específicos, como el mecA en cepas MRSA (Staphylococcus aureus resistente a meticilina).
Clasificación de Antibióticos según su Mecanismo de Acción
Los antibióticos se clasifican en varios grupos según cómo inhiben o eliminan a las bacterias:
-
Inhibidores de la síntesis de la pared celular
- Ejemplos: Penicilinas, cefalosporinas, carbapenems, vancomicina
- Mecanismo: Interfieren con la formación de peptidoglicano, debilitando la estructura y provocando lisis celular
-
Inhibidores de la síntesis de proteínas
- Aminoglucósidos (estreptomicina, gentamicina)
- Tetraciclinas (doxiciclina, tetraciclina)
- Macrólidos (eritromicina, azitromicina)
- Mecanismo: Se unen a los ribosomas bacterianos e interfieren con la síntesis proteica
-
Inhibidores de la síntesis de ácido nucleico
- Quinolonas (ciprofloxacina, levofloxacina): inhiben la ADN girasa
- Rifamicinas (rifampicina): inhiben la ARN polimerasa
-
Inhibidores de la síntesis de metabolitos
- Sulfonamidas y Trimetoprim: interfieren con la síntesis de ácido fólico
-
Inhibidores de la membrana celular
- Polimixinas (colistina): desestabilizan la membrana celular bacteriana
⚠️ Importante: El uso indiscriminado de antibióticos ha acelerado la aparición de resistencias bacterianas, lo que representa uno de los mayores desafíos actuales para la medicina veterinaria y humana.

Mecanismos de Resistencia Antibiótica y Diagnóstico de Tuberculosis Bovina
Mecanismos de Resistencia a Antibióticos
Las bacterias desarrollan resistencia a los antibióticos mediante diversos mecanismos:
-
Mutaciones genéticas: Alteraciones espontáneas en genes que codifican proteínas diana, reduciendo la afinidad del antibiótico por su blanco.
-
Transferencia horizontal de genes: Intercambio de material genético entre bacterias mediante:
- Conjugación: Transferencia directa de plásmidos con genes de resistencia
- Transformación: Captación de ADN con genes de resistencia del ambiente
- Transducción: Transferencia de genes mediante bacteriófagos
-
Enzimas inactivadoras: Producción de enzimas como las beta-lactamasas que degradan antibióticos antes de que ejerzan su acción.
-
Bombas de eflujo: Sistemas que expulsan activamente los antibióticos fuera de la célula, reduciendo su concentración intracelular.
-
Modificación del sitio diana: Alteraciones estructurales que impiden la unión del antibiótico a su sitio de acción.
Diagnóstico de Tuberculosis Bovina
Un artículo sobre el diagnóstico de tuberculosis bovina mediante aislamiento bacteriológico e histopatológico en vacunos reactores a la prueba de tuberculina destaca la importancia de confirmar los resultados de esta prueba mediante métodos de laboratorio, ya que la reactividad puede deberse a micobacterias no patógenas o reacciones inespecíficas.
El aislamiento bacteriológico implica obtener muestras de tejidos con lesiones sugestivas, procesarlas en condiciones de bioseguridad y cultivarlas en medios especializados como Löwenstein-Jensen. Las colonias características de Mycobacterium bovis son de crecimiento lento y morfología rugosa.
El análisis histopatológico complementa el diagnóstico mediante observación microscópica de cortes de tejido teñidos con hematoxilina-eosina y Ziehl-Neelsen, buscando granulomas típicos con células epitelioides, linfocitos y células gigantes de Langhans. La presencia de bacilos ácido-alcohol resistentes confirma la sospecha.
🔍 Aplicación clínica: Un enfoque diagnóstico que combine técnicas microbiológicas e histopatológicas aumenta significativamente la precisión en la identificación de patógenos como Mycobacterium bovis, fundamental para programas de control y erradicación de tuberculosis bovina.

Objetivos y Métodos de Diagnóstico Bacteriano
Objetivo Principal
El diagnóstico bacteriológico busca proporcionar un análisis exhaustivo de los métodos microbiológicos utilizados para identificar infecciones bacterianas, enfatizando la importancia de un diagnóstico preciso en salud pública y veterinaria. Esto se logra mediante la evaluación de técnicas de aislamiento, identificación y determinación de sensibilidad a antibióticos.
Materiales y Métodos
Materiales utilizados:
- Instrumentos: Asas microbiológicas, mechero Bunsen, pinzas, portaobjetos, microscopio
- Cultivos de diversos microorganismos y hongo dermatofito
- Medios de cultivo: Agar MacConkey, SS, XLD, Salado Manitol, TSI, Müller Hinton
- Caldos: Nutritivo, Lauril Sulfato
- Reactivos para tinción: Cristal Violeta, Solución de Yodo, Alcohol-acetona, Safranina
- Discos para antibiogramas
Metodología:
1. Tinción de Gram
Esta técnica diferencial permite clasificar bacterias en dos grandes grupos: Gram positivas y Gram negativas. El procedimiento incluye:
- Preparación de un extendido bacteriano en portaobjetos
- Aplicación secuencial de cristal violeta (1 minuto)
- Fijación con solución de yodo (1 minuto)
- Decoloración con alcohol-acetona
- Contraste con safranina
- Observación al microscopio con objetivo de 100X usando aceite de inmersión
Las bacterias Gram positivas retienen el complejo cristal violeta-yodo y aparecen violetas/púrpuras, mientras que las Gram negativas se decoloran y toman el color rosa/rojo de la safranina. Esta diferencia refleja la estructura de la pared celular: gruesa con múltiples capas de peptidoglicano en Gram positivas, y delgada con membrana externa adicional en Gram negativas.
💡 Consejo práctico: La correcta decoloración es el paso más crítico en la tinción de Gram. Un tiempo insuficiente puede dar falsos positivos en bacterias Gram negativas, mientras que un tiempo excesivo puede dar falsos negativos en Gram positivas.

Técnicas de Siembra y Antibiograma
Siembra por Agotamiento en Medio Sólido
Esta técnica permite obtener colonias aisladas a partir de una muestra con alta densidad bacteriana. El procedimiento incluye:
- Calentar el asa de siembra al rojo vivo en la llama del mechero
- Enfriar el asa tocando un área del agar alejada de la zona de siembra
- Tomar una muestra del cultivo bacteriano
- Realizar estrías en el agar nuevo, diluyendo progresivamente la muestra
- Incubar la placa invertida a 37°C
Esta técnica facilita el aislamiento de colonias individuales, permitiendo estudiar sus características morfológicas y realizar pruebas de identificación específicas.
Siembra Masiva y Antibiograma
La prueba de sensibilidad a antibióticos (antibiograma) es crucial para determinar la eficacia de diferentes antibióticos contra un patógeno específico. El método de Kirby-Bauer implica:
- Recoger muestra bacteriana con un hisopo estéril
- Transferir la bacteria a un tubo con caldo de cultivo hasta obtener turbidez adecuada
- Realizar siembra masiva cubriendo toda la superficie del agar Müller Hinton
- Colocar discos de antibióticos estratégicamente sobre la superficie sembrada
- Incubar a 37°C para observar los halos de inhibición
El tamaño de los halos de inhibición (zonas sin crecimiento alrededor de los discos) indica la sensibilidad de la bacteria al antibiótico: a mayor halo, mayor sensibilidad.
Siembra de Hongos Dermatofitos
Para el cultivo de hongos dermatofitos, se empleó una metodología específica:
- Obtener muestra de pelos y escamas de un gato con sospecha de infección fúngica
- Sembrar en agar nutritivo específico para hongos
- Distribuir la muestra para favorecer el crecimiento
- Sellar e incubar la caja a 25°C durante 7 días
Los hongos dermatofitos requieren menor temperatura y mayor tiempo de incubación que las bacterias, adaptándose así a sus condiciones óptimas de crecimiento.
⚠️ Precaución: Al trabajar con muestras clínicas potencialmente infecciosas, siempre deben seguirse estrictos protocolos de bioseguridad para evitar contaminaciones cruzadas o infecciones accidentales.

Resultados de la Tinción de Gram
La tinción de Gram reveló características morfológicas distintivas de las tres bacterias estudiadas:
Bacterias Gram Positivas: Staphylococcus aureus
En las muestras de los grupos 1 y 4, se observaron cocos Gram positivos agrupados en racimos característicos. Estas bacterias retienen el colorante cristal violeta y aparecen de color púrpura o violeta debido a su pared celular gruesa compuesta por múltiples capas de peptidoglicano.
La estructura densa de peptidoglicano en S. aureus impide que el complejo cristal violeta-yodo se elimine durante la decoloración con alcohol, manteniéndose el color púrpura característico.
Bacterias Gram Negativas: Salmonella spp. y Escherichia coli
Para Escherichia coli (grupo 5), la tinción mostró bacilos Gram negativos de color rosa/rojo, característicos de bacterias que no retienen el cristal violeta tras la decoloración y se tiñen con el colorante de contraste (safranina).
Se observó un error en la tinción de Salmonella spp. (grupos 2 y 3), ya que apareció con coloración púrpura o violeta mezclada con rosado, cuando debería verse completamente rosa/roja por ser Gram negativa. Este error podría deberse a:
- Decoloración insuficiente con alcohol
- Preparación de muestra demasiado gruesa
- Posible contaminación con bacterias Gram positivas
Las bacterias Gram negativas como Salmonella y E. coli poseen una pared celular delgada con pocas capas de peptidoglicano y una membrana externa adicional de lipopolisacáridos, que les confiere mayor resistencia a ciertos antibióticos y agentes químicos.
💡 Punto clave: Los errores en la tinción de Gram pueden conducir a diagnósticos incorrectos. Una decoloración insuficiente es la causa más común de falsos positivos en bacterias Gram negativas, por lo que este paso debe realizarse con especial cuidado.

Resultados en Medios de Cultivo
Medio XLD (Xilosa Lisina Desoxicolato)
Este medio selectivo y diferencial resultó positivo para las bacterias Gram negativas (Salmonella spp. y Escherichia coli) y negativo para la bacteria Gram positiva (Staphylococcus aureus).
En las placas se observaron características distintivas:
- Salmonella spp.: Colonias rojas, transparentes, con centro negro (producción de H₂S)
- E. coli: Colonias amarillas y opacas, con zona de precipitación amarilla alrededor debido a la fermentación de xilosa, lactosa y sacarosa, que acidifica el medio
La selectividad del XLD está dada por el desoxicolato de sodio, que inhibe bacterias Gram positivas como S. aureus. Su capacidad diferencial se basa en la fermentación de xilosa y la decarboxilación de lisina, permitiendo distinguir Salmonella (colonias con centro negro) de otras enterobacterias.
Agar Sangre
En este medio enriquecido, se observaron diferentes patrones de hemólisis:
-
Staphylococcus aureus (grupos 1 y 4): Hemólisis beta (β), mostrando un halo claro y brillante alrededor de las colonias, indicativo de lisis total de glóbulos rojos.
-
Salmonella spp. (grupos 2 y 3): Hemólisis gamma (γ), sin modificaciones de color ni aspecto alrededor de las colonias, indicando ausencia de lisis de glóbulos rojos.
-
Escherichia coli (grupo 5): Mostró un patrón mixto con características de hemólisis alfa (α) —halo verdoso por oxidación de hemoglobina a metahemoglobina— y hemólisis beta (β) —halo claro y brillante—.
Estas características hemolíticas son fundamentales para la identificación presuntiva de bacterias, especialmente en el caso de Staphylococcus y Streptococcus.
🔍 Observación importante: La atmósfera de incubación puede influir significativamente en el tipo de hemólisis. Para obtener resultados óptimos con estreptococos beta-hemolíticos, es recomendable incubar las placas en atmósfera con CO₂ o en anaerobiosis.



















Pensamos que nunca lo preguntarías...
¿Qué es Knowunity AI companion?
Nuestro compañero de IA está específicamente adaptado a las necesidades de los estudiantes. Basándonos en los millones de contenidos que tenemos en la plataforma, podemos dar a los estudiantes respuestas realmente significativas y relevantes. Pero no se trata solo de respuestas, el compañero también guía a los estudiantes a través de sus retos de aprendizaje diarios, con planes de aprendizaje personalizados, cuestionarios o contenidos en el chat y una personalización del 100% basada en las habilidades y el desarrollo de los estudiantes.
¿Dónde puedo descargar la app Knowunity?
Puedes descargar la app en Google Play Store y Apple App Store.
¿Knowunity es totalmente gratuito?
¡Sí lo es! Tienes acceso totalmente gratuito a todo el contenido de la app, puedes chatear con otros alumnos y recibir ayuda inmeditamente. Puedes ganar dinero utilizando la aplicación, que te permitirá acceder a determinadas funciones.
Contenidos más populares de Química
9Contenidos más populares
9¿No encuentras lo que buscas? Explora otros temas.
Mira lo que dicen nuestros usuarios. Les encantó — y a ti también te encantará.
La app es muy fácil de usar y está muy bien diseñada. Hasta ahora he encontrado todo lo que estaba buscando y he podido aprender mucho de las presentaciones. Definitivamente utilizaré la aplicación para un examen de clase. Y, por supuesto, también me sirve mucho de inspiración.
Esta app es realmente genial. Hay tantos apuntes de clase y ayuda [...]. Tengo problemas con matemáticas, por ejemplo, y la aplicación tiene muchas opciones de ayuda. Gracias a Knowunity, he mejorado en mates. Se la recomiendo a todo el mundo.
Vaya, estoy realmente sorprendida. Acabo de probar la app porque la he visto anunciada muchas veces y me he quedado absolutamente alucinada. Esta app es LA AYUDA que quieres para el insti y, sobre todo, ofrece muchísimas cosas, como ejercicios y hojas informativas, que a mí personalmente me han sido MUY útiles.
Análisis de Microbiología Veterinaria: Informe del Laboratorio
Las infecciones bacterianas representan un desafío importante tanto para la salud animal como humana. El diagnóstico bacteriano de enfermedades infecciosas involucra técnicas específicas para aislar, identificar y determinar la sensibilidad a antibióticos de los patógenos, permitiendo establecer tratamientos efectivos y... Mostrar más

Inscríbete para ver los apuntes. ¡Es gratis!
- Acceso a todos los documentos
- Mejora tus notas
- Únete a millones de estudiantes
Introducción a la Práctica de Diagnóstico Bacteriano
El diagnóstico bacteriano es fundamental para identificar agentes patógenos y establecer tratamientos efectivos en medicina veterinaria. Esta práctica, desarrollada en la Universidad de Pamplona (Facultad de Ciencias Agrarias, Departamento de Medicina Veterinaria), busca explorar las técnicas fundamentales para el aislamiento, identificación y caracterización de bacterias causantes de enfermedades infecciosas.
A través de procedimientos como la siembra en medios de cultivo, tinciones y pruebas de sensibilidad a antibióticos, los estudiantes adquieren habilidades esenciales para el diagnóstico microbiológico. Estas competencias son indispensables para futuros médicos veterinarios, quienes enfrentarán constantemente enfermedades de origen bacteriano en su práctica profesional.
El dominio de estas técnicas no solo permite identificar al patógeno causante de una infección, sino también determinar el tratamiento más adecuado, contribuyendo directamente a la salud animal y la prevención de zoonosis.
💡 Dato clave: Las técnicas de diagnóstico bacteriano constituyen la base para el control y erradicación de enfermedades infecciosas, siendo fundamentales tanto para la salud animal como para la salud pública.

Inscríbete para ver los apuntes. ¡Es gratis!
- Acceso a todos los documentos
- Mejora tus notas
- Únete a millones de estudiantes
Fundamentos del Diagnóstico Bacteriano
Las infecciones bacterianas pueden originarse de dos maneras principales: endógenas (causadas por la microflora normal del huésped) o exógenas (provenientes del ambiente). En áreas desarrolladas, predominan las infecciones endógenas, mientras que en regiones con mayores índices de pobreza, son más comunes las exógenas.
Las rutas de transmisión bacteriana varían considerablemente e incluyen la vía fecal-oral, aérea, transcutánea, parenteral, sexual y mediante vectores como artrópodos. Conocer estas vías es esencial para establecer medidas efectivas de control y prevención.
La siembra bacteriana es el proceso de colocar bacterias en medios de cultivo para su estudio. Esto puede realizarse a partir de muestras biológicas (como orina o pus), para control de calidad (en alimentos o medicamentos) o mediante subcultivos. La identificación bacteriana requiere conocer tanto su morfología microscópica como macroscópica, observando las características de las colonias en los medios de cultivo.
Las bacterias poseen una notable versatilidad para utilizar diversos compuestos nutritivos, desde moléculas inorgánicas simples hasta compuestos orgánicos complejos. Esta capacidad diferencial de utilización de nutrientes constituye la base para su identificación tradicional en el laboratorio.
🔬 Perspectiva práctica: El diagnóstico bacteriano no solo identifica al patógeno, sino que también proporciona información crucial sobre su resistencia a antibióticos, permitiendo seleccionar el tratamiento más efectivo y evitando la propagación de cepas resistentes.

Inscríbete para ver los apuntes. ¡Es gratis!
- Acceso a todos los documentos
- Mejora tus notas
- Únete a millones de estudiantes
Tipos de Medios de Cultivo y su Utilidad Diagnóstica
Los medios de cultivo son fundamentales en el diagnóstico bacteriológico y pueden diseñarse para diversos propósitos: aislar tipos bacterianos específicos, diferenciar grupos relacionados, identificar microorganismos en muestras ambientales, evaluar efectos de sustancias antimicrobianas o caracterizar bacterias según sus capacidades metabólicas.
Medios Enriquecidos
Los medios enriquecidos están formulados para fomentar el crecimiento de bacterias exigentes que requieren nutrientes específicos. Contienen componentes adicionales como suero sanguíneo o extractos de tejidos que proporcionan una rica fuente nutritiva.
Ejemplos destacados incluyen el agar sangre, que permite el crecimiento de patógenos exigentes como Streptococcus pneumoniae y facilita la identificación de patrones de hemólisis (α, β o γ). Otro ejemplo importante es el agar chocolate, enriquecido con sangre calentada que libera factores esenciales para bacterias como Haemophilus influenzae.
A diferencia de los medios selectivos, los medios enriquecidos no están diseñados para inhibir microorganismos, sino para proporcionar un ambiente óptimo para el crecimiento de aquellos con requerimientos nutricionales específicos.
Medios Selectivos
Estos medios contienen sustancias que inhiben el crecimiento de ciertos microorganismos mientras permiten el desarrollo de otros. Incluyen sales, colorantes, antibióticos u otros compuestos químicos que actúan como agentes selectivos.
El agar MacConkey es un ejemplo clásico, que selecciona bacterias gramnegativas al contener sales biliares y cristal violeta que inhiben bacterias grampositivas. El agar manitol salado es otro medio selectivo importante, cuya alta concentración de sal permite el crecimiento de estafilococos mientras inhibe otras bacterias.
Estos medios son invaluables en microbiología clínica para aislar patógenos específicos de muestras complejas como sangre o heces, donde pueden existir poblaciones microbianas mixtas.

Inscríbete para ver los apuntes. ¡Es gratis!
- Acceso a todos los documentos
- Mejora tus notas
- Únete a millones de estudiantes
Medios Diferenciales e Identificación Bacteriana
Medios Diferenciales
Los medios diferenciales permiten distinguir entre especies bacterianas basándose en reacciones bioquímicas visibles. Contienen sustratos o indicadores que producen cambios visuales cuando son metabolizados por ciertos microorganismos, facilitando la identificación de diferentes colonias en muestras mixtas.
El agar MacConkey, además de ser selectivo, es también diferencial: las bacterias fermentadoras de lactosa forman colonias rojizas, mientras que las no fermentadoras aparecen incoloras. Otro ejemplo es el agar eosina-azul de metileno (EMB), que diferencia Escherichia coli (colonias verde metálico) de otras bacterias gramnegativas no fermentadoras.
Estos medios resaltan diferencias metabólicas entre microorganismos y facilitan la identificación rápida en laboratorios clínicos y de diagnóstico.
Identificación de Grupos Bacterianos Específicos
Bacterias Hemolíticas
Se identifican principalmente en agar sangre, observando el tipo de hemólisis:
- β-hemólisis: Halo claro alrededor de las colonias (ej. Streptococcus pyogenes)
- α-hemólisis: Halo verdoso alrededor de las colonias (ej. Streptococcus pneumoniae)
- γ-hemólisis: Ausencia de hemólisis
Enterobacterias
Se utilizan medios como agar MacConkey y EMB para diferenciar fermentadoras de lactosa de no fermentadoras. Las pruebas bioquímicas complementarias incluyen catalasa, oxidasa, ureasa y fermentación de azúcares. Sistemas como API 20E permiten la caracterización de enterobacterias mediante pruebas bioquímicas miniaturizadas.
Anaerobios
Requieren condiciones especiales de cultivo con baja o ausencia de oxígeno. Se utilizan medios específicos como agar Schaedler o tioglicolato, y sistemas de incubación anaeróbica. Las pruebas de identificación incluyen catalasa (generalmente negativa), esporulación y métodos moleculares como PCR.
💡 Recuerda: La correcta selección del medio de cultivo es fundamental para el aislamiento e identificación de bacterias patógenas, ya que cada medio está diseñado para favorecer el crecimiento de ciertos microorganismos mientras inhibe o diferencia otros.

Inscríbete para ver los apuntes. ¡Es gratis!
- Acceso a todos los documentos
- Mejora tus notas
- Únete a millones de estudiantes
Identificación de Staphylococcus y Clasificación de Antibióticos
Identificación de Staphylococcus
Para identificar bacterias del género Staphylococcus, se emplean pruebas específicas como:
- Cultivo en agar sangre y agar manitol salado: Staphylococcus aureus fermenta manitol, produciendo un cambio de color en el medio.
- Prueba de catalasa: Permite diferenciar estafilococos (catalasa positivos) de estreptococos (catalasa negativos).
- Prueba de coagulasa: S. aureus es coagulasa positivo, diferenciándolo de otras especies como S. epidermidis y S. saprophyticus.
- Técnicas moleculares: PCR para genes específicos, como el mecA en cepas MRSA (Staphylococcus aureus resistente a meticilina).
Clasificación de Antibióticos según su Mecanismo de Acción
Los antibióticos se clasifican en varios grupos según cómo inhiben o eliminan a las bacterias:
-
Inhibidores de la síntesis de la pared celular
- Ejemplos: Penicilinas, cefalosporinas, carbapenems, vancomicina
- Mecanismo: Interfieren con la formación de peptidoglicano, debilitando la estructura y provocando lisis celular
-
Inhibidores de la síntesis de proteínas
- Aminoglucósidos (estreptomicina, gentamicina)
- Tetraciclinas (doxiciclina, tetraciclina)
- Macrólidos (eritromicina, azitromicina)
- Mecanismo: Se unen a los ribosomas bacterianos e interfieren con la síntesis proteica
-
Inhibidores de la síntesis de ácido nucleico
- Quinolonas (ciprofloxacina, levofloxacina): inhiben la ADN girasa
- Rifamicinas (rifampicina): inhiben la ARN polimerasa
-
Inhibidores de la síntesis de metabolitos
- Sulfonamidas y Trimetoprim: interfieren con la síntesis de ácido fólico
-
Inhibidores de la membrana celular
- Polimixinas (colistina): desestabilizan la membrana celular bacteriana
⚠️ Importante: El uso indiscriminado de antibióticos ha acelerado la aparición de resistencias bacterianas, lo que representa uno de los mayores desafíos actuales para la medicina veterinaria y humana.

Inscríbete para ver los apuntes. ¡Es gratis!
- Acceso a todos los documentos
- Mejora tus notas
- Únete a millones de estudiantes
Mecanismos de Resistencia Antibiótica y Diagnóstico de Tuberculosis Bovina
Mecanismos de Resistencia a Antibióticos
Las bacterias desarrollan resistencia a los antibióticos mediante diversos mecanismos:
-
Mutaciones genéticas: Alteraciones espontáneas en genes que codifican proteínas diana, reduciendo la afinidad del antibiótico por su blanco.
-
Transferencia horizontal de genes: Intercambio de material genético entre bacterias mediante:
- Conjugación: Transferencia directa de plásmidos con genes de resistencia
- Transformación: Captación de ADN con genes de resistencia del ambiente
- Transducción: Transferencia de genes mediante bacteriófagos
-
Enzimas inactivadoras: Producción de enzimas como las beta-lactamasas que degradan antibióticos antes de que ejerzan su acción.
-
Bombas de eflujo: Sistemas que expulsan activamente los antibióticos fuera de la célula, reduciendo su concentración intracelular.
-
Modificación del sitio diana: Alteraciones estructurales que impiden la unión del antibiótico a su sitio de acción.
Diagnóstico de Tuberculosis Bovina
Un artículo sobre el diagnóstico de tuberculosis bovina mediante aislamiento bacteriológico e histopatológico en vacunos reactores a la prueba de tuberculina destaca la importancia de confirmar los resultados de esta prueba mediante métodos de laboratorio, ya que la reactividad puede deberse a micobacterias no patógenas o reacciones inespecíficas.
El aislamiento bacteriológico implica obtener muestras de tejidos con lesiones sugestivas, procesarlas en condiciones de bioseguridad y cultivarlas en medios especializados como Löwenstein-Jensen. Las colonias características de Mycobacterium bovis son de crecimiento lento y morfología rugosa.
El análisis histopatológico complementa el diagnóstico mediante observación microscópica de cortes de tejido teñidos con hematoxilina-eosina y Ziehl-Neelsen, buscando granulomas típicos con células epitelioides, linfocitos y células gigantes de Langhans. La presencia de bacilos ácido-alcohol resistentes confirma la sospecha.
🔍 Aplicación clínica: Un enfoque diagnóstico que combine técnicas microbiológicas e histopatológicas aumenta significativamente la precisión en la identificación de patógenos como Mycobacterium bovis, fundamental para programas de control y erradicación de tuberculosis bovina.

Inscríbete para ver los apuntes. ¡Es gratis!
- Acceso a todos los documentos
- Mejora tus notas
- Únete a millones de estudiantes
Objetivos y Métodos de Diagnóstico Bacteriano
Objetivo Principal
El diagnóstico bacteriológico busca proporcionar un análisis exhaustivo de los métodos microbiológicos utilizados para identificar infecciones bacterianas, enfatizando la importancia de un diagnóstico preciso en salud pública y veterinaria. Esto se logra mediante la evaluación de técnicas de aislamiento, identificación y determinación de sensibilidad a antibióticos.
Materiales y Métodos
Materiales utilizados:
- Instrumentos: Asas microbiológicas, mechero Bunsen, pinzas, portaobjetos, microscopio
- Cultivos de diversos microorganismos y hongo dermatofito
- Medios de cultivo: Agar MacConkey, SS, XLD, Salado Manitol, TSI, Müller Hinton
- Caldos: Nutritivo, Lauril Sulfato
- Reactivos para tinción: Cristal Violeta, Solución de Yodo, Alcohol-acetona, Safranina
- Discos para antibiogramas
Metodología:
1. Tinción de Gram
Esta técnica diferencial permite clasificar bacterias en dos grandes grupos: Gram positivas y Gram negativas. El procedimiento incluye:
- Preparación de un extendido bacteriano en portaobjetos
- Aplicación secuencial de cristal violeta (1 minuto)
- Fijación con solución de yodo (1 minuto)
- Decoloración con alcohol-acetona
- Contraste con safranina
- Observación al microscopio con objetivo de 100X usando aceite de inmersión
Las bacterias Gram positivas retienen el complejo cristal violeta-yodo y aparecen violetas/púrpuras, mientras que las Gram negativas se decoloran y toman el color rosa/rojo de la safranina. Esta diferencia refleja la estructura de la pared celular: gruesa con múltiples capas de peptidoglicano en Gram positivas, y delgada con membrana externa adicional en Gram negativas.
💡 Consejo práctico: La correcta decoloración es el paso más crítico en la tinción de Gram. Un tiempo insuficiente puede dar falsos positivos en bacterias Gram negativas, mientras que un tiempo excesivo puede dar falsos negativos en Gram positivas.

Inscríbete para ver los apuntes. ¡Es gratis!
- Acceso a todos los documentos
- Mejora tus notas
- Únete a millones de estudiantes
Técnicas de Siembra y Antibiograma
Siembra por Agotamiento en Medio Sólido
Esta técnica permite obtener colonias aisladas a partir de una muestra con alta densidad bacteriana. El procedimiento incluye:
- Calentar el asa de siembra al rojo vivo en la llama del mechero
- Enfriar el asa tocando un área del agar alejada de la zona de siembra
- Tomar una muestra del cultivo bacteriano
- Realizar estrías en el agar nuevo, diluyendo progresivamente la muestra
- Incubar la placa invertida a 37°C
Esta técnica facilita el aislamiento de colonias individuales, permitiendo estudiar sus características morfológicas y realizar pruebas de identificación específicas.
Siembra Masiva y Antibiograma
La prueba de sensibilidad a antibióticos (antibiograma) es crucial para determinar la eficacia de diferentes antibióticos contra un patógeno específico. El método de Kirby-Bauer implica:
- Recoger muestra bacteriana con un hisopo estéril
- Transferir la bacteria a un tubo con caldo de cultivo hasta obtener turbidez adecuada
- Realizar siembra masiva cubriendo toda la superficie del agar Müller Hinton
- Colocar discos de antibióticos estratégicamente sobre la superficie sembrada
- Incubar a 37°C para observar los halos de inhibición
El tamaño de los halos de inhibición (zonas sin crecimiento alrededor de los discos) indica la sensibilidad de la bacteria al antibiótico: a mayor halo, mayor sensibilidad.
Siembra de Hongos Dermatofitos
Para el cultivo de hongos dermatofitos, se empleó una metodología específica:
- Obtener muestra de pelos y escamas de un gato con sospecha de infección fúngica
- Sembrar en agar nutritivo específico para hongos
- Distribuir la muestra para favorecer el crecimiento
- Sellar e incubar la caja a 25°C durante 7 días
Los hongos dermatofitos requieren menor temperatura y mayor tiempo de incubación que las bacterias, adaptándose así a sus condiciones óptimas de crecimiento.
⚠️ Precaución: Al trabajar con muestras clínicas potencialmente infecciosas, siempre deben seguirse estrictos protocolos de bioseguridad para evitar contaminaciones cruzadas o infecciones accidentales.

Inscríbete para ver los apuntes. ¡Es gratis!
- Acceso a todos los documentos
- Mejora tus notas
- Únete a millones de estudiantes
Resultados de la Tinción de Gram
La tinción de Gram reveló características morfológicas distintivas de las tres bacterias estudiadas:
Bacterias Gram Positivas: Staphylococcus aureus
En las muestras de los grupos 1 y 4, se observaron cocos Gram positivos agrupados en racimos característicos. Estas bacterias retienen el colorante cristal violeta y aparecen de color púrpura o violeta debido a su pared celular gruesa compuesta por múltiples capas de peptidoglicano.
La estructura densa de peptidoglicano en S. aureus impide que el complejo cristal violeta-yodo se elimine durante la decoloración con alcohol, manteniéndose el color púrpura característico.
Bacterias Gram Negativas: Salmonella spp. y Escherichia coli
Para Escherichia coli (grupo 5), la tinción mostró bacilos Gram negativos de color rosa/rojo, característicos de bacterias que no retienen el cristal violeta tras la decoloración y se tiñen con el colorante de contraste (safranina).
Se observó un error en la tinción de Salmonella spp. (grupos 2 y 3), ya que apareció con coloración púrpura o violeta mezclada con rosado, cuando debería verse completamente rosa/roja por ser Gram negativa. Este error podría deberse a:
- Decoloración insuficiente con alcohol
- Preparación de muestra demasiado gruesa
- Posible contaminación con bacterias Gram positivas
Las bacterias Gram negativas como Salmonella y E. coli poseen una pared celular delgada con pocas capas de peptidoglicano y una membrana externa adicional de lipopolisacáridos, que les confiere mayor resistencia a ciertos antibióticos y agentes químicos.
💡 Punto clave: Los errores en la tinción de Gram pueden conducir a diagnósticos incorrectos. Una decoloración insuficiente es la causa más común de falsos positivos en bacterias Gram negativas, por lo que este paso debe realizarse con especial cuidado.

Inscríbete para ver los apuntes. ¡Es gratis!
- Acceso a todos los documentos
- Mejora tus notas
- Únete a millones de estudiantes
Resultados en Medios de Cultivo
Medio XLD (Xilosa Lisina Desoxicolato)
Este medio selectivo y diferencial resultó positivo para las bacterias Gram negativas (Salmonella spp. y Escherichia coli) y negativo para la bacteria Gram positiva (Staphylococcus aureus).
En las placas se observaron características distintivas:
- Salmonella spp.: Colonias rojas, transparentes, con centro negro (producción de H₂S)
- E. coli: Colonias amarillas y opacas, con zona de precipitación amarilla alrededor debido a la fermentación de xilosa, lactosa y sacarosa, que acidifica el medio
La selectividad del XLD está dada por el desoxicolato de sodio, que inhibe bacterias Gram positivas como S. aureus. Su capacidad diferencial se basa en la fermentación de xilosa y la decarboxilación de lisina, permitiendo distinguir Salmonella (colonias con centro negro) de otras enterobacterias.
Agar Sangre
En este medio enriquecido, se observaron diferentes patrones de hemólisis:
-
Staphylococcus aureus (grupos 1 y 4): Hemólisis beta (β), mostrando un halo claro y brillante alrededor de las colonias, indicativo de lisis total de glóbulos rojos.
-
Salmonella spp. (grupos 2 y 3): Hemólisis gamma (γ), sin modificaciones de color ni aspecto alrededor de las colonias, indicando ausencia de lisis de glóbulos rojos.
-
Escherichia coli (grupo 5): Mostró un patrón mixto con características de hemólisis alfa (α) —halo verdoso por oxidación de hemoglobina a metahemoglobina— y hemólisis beta (β) —halo claro y brillante—.
Estas características hemolíticas son fundamentales para la identificación presuntiva de bacterias, especialmente en el caso de Staphylococcus y Streptococcus.
🔍 Observación importante: La atmósfera de incubación puede influir significativamente en el tipo de hemólisis. Para obtener resultados óptimos con estreptococos beta-hemolíticos, es recomendable incubar las placas en atmósfera con CO₂ o en anaerobiosis.

Inscríbete para ver los apuntes. ¡Es gratis!
- Acceso a todos los documentos
- Mejora tus notas
- Únete a millones de estudiantes

Inscríbete para ver los apuntes. ¡Es gratis!
- Acceso a todos los documentos
- Mejora tus notas
- Únete a millones de estudiantes

Inscríbete para ver los apuntes. ¡Es gratis!
- Acceso a todos los documentos
- Mejora tus notas
- Únete a millones de estudiantes

Inscríbete para ver los apuntes. ¡Es gratis!
- Acceso a todos los documentos
- Mejora tus notas
- Únete a millones de estudiantes

Inscríbete para ver los apuntes. ¡Es gratis!
- Acceso a todos los documentos
- Mejora tus notas
- Únete a millones de estudiantes

Inscríbete para ver los apuntes. ¡Es gratis!
- Acceso a todos los documentos
- Mejora tus notas
- Únete a millones de estudiantes

Inscríbete para ver los apuntes. ¡Es gratis!
- Acceso a todos los documentos
- Mejora tus notas
- Únete a millones de estudiantes
Inscríbete para ver los apuntes. ¡Es gratis!
- Acceso a todos los documentos
- Mejora tus notas
- Únete a millones de estudiantes
Inscríbete para ver los apuntes. ¡Es gratis!
- Acceso a todos los documentos
- Mejora tus notas
- Únete a millones de estudiantes

Inscríbete para ver los apuntes. ¡Es gratis!
- Acceso a todos los documentos
- Mejora tus notas
- Únete a millones de estudiantes

Inscríbete para ver los apuntes. ¡Es gratis!
- Acceso a todos los documentos
- Mejora tus notas
- Únete a millones de estudiantes

Inscríbete para ver los apuntes. ¡Es gratis!
- Acceso a todos los documentos
- Mejora tus notas
- Únete a millones de estudiantes

Inscríbete para ver los apuntes. ¡Es gratis!
- Acceso a todos los documentos
- Mejora tus notas
- Únete a millones de estudiantes

Inscríbete para ver los apuntes. ¡Es gratis!
- Acceso a todos los documentos
- Mejora tus notas
- Únete a millones de estudiantes

Inscríbete para ver los apuntes. ¡Es gratis!
- Acceso a todos los documentos
- Mejora tus notas
- Únete a millones de estudiantes

Inscríbete para ver los apuntes. ¡Es gratis!
- Acceso a todos los documentos
- Mejora tus notas
- Únete a millones de estudiantes

Inscríbete para ver los apuntes. ¡Es gratis!
- Acceso a todos los documentos
- Mejora tus notas
- Únete a millones de estudiantes

Inscríbete para ver los apuntes. ¡Es gratis!
- Acceso a todos los documentos
- Mejora tus notas
- Únete a millones de estudiantes

Inscríbete para ver los apuntes. ¡Es gratis!
- Acceso a todos los documentos
- Mejora tus notas
- Únete a millones de estudiantes
Pensamos que nunca lo preguntarías...
¿Qué es Knowunity AI companion?
Nuestro compañero de IA está específicamente adaptado a las necesidades de los estudiantes. Basándonos en los millones de contenidos que tenemos en la plataforma, podemos dar a los estudiantes respuestas realmente significativas y relevantes. Pero no se trata solo de respuestas, el compañero también guía a los estudiantes a través de sus retos de aprendizaje diarios, con planes de aprendizaje personalizados, cuestionarios o contenidos en el chat y una personalización del 100% basada en las habilidades y el desarrollo de los estudiantes.
¿Dónde puedo descargar la app Knowunity?
Puedes descargar la app en Google Play Store y Apple App Store.
¿Knowunity es totalmente gratuito?
¡Sí lo es! Tienes acceso totalmente gratuito a todo el contenido de la app, puedes chatear con otros alumnos y recibir ayuda inmeditamente. Puedes ganar dinero utilizando la aplicación, que te permitirá acceder a determinadas funciones.
Contenidos más populares de Química
9Contenidos más populares
9¿No encuentras lo que buscas? Explora otros temas.
Mira lo que dicen nuestros usuarios. Les encantó — y a ti también te encantará.
La app es muy fácil de usar y está muy bien diseñada. Hasta ahora he encontrado todo lo que estaba buscando y he podido aprender mucho de las presentaciones. Definitivamente utilizaré la aplicación para un examen de clase. Y, por supuesto, también me sirve mucho de inspiración.
Esta app es realmente genial. Hay tantos apuntes de clase y ayuda [...]. Tengo problemas con matemáticas, por ejemplo, y la aplicación tiene muchas opciones de ayuda. Gracias a Knowunity, he mejorado en mates. Se la recomiendo a todo el mundo.
Vaya, estoy realmente sorprendida. Acabo de probar la app porque la he visto anunciada muchas veces y me he quedado absolutamente alucinada. Esta app es LA AYUDA que quieres para el insti y, sobre todo, ofrece muchísimas cosas, como ejercicios y hojas informativas, que a mí personalmente me han sido MUY útiles.